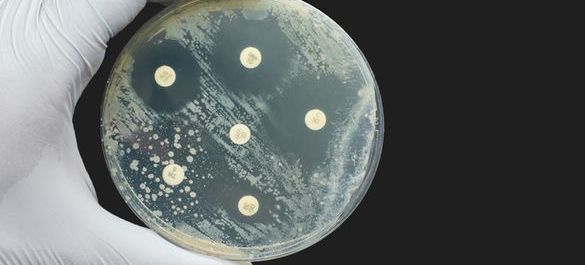
iStockNicolae Malancea_AMR.jpg

Antimicrobial Resistance
Explore our policy work on AMR
The threat of antimicrobial resistance (AMR) has now been recognised globally and it is estimated that 10 million people a year will die due to antimicrobial resistance by 2050 if no urgent action is taken. Explore more of the Microbiology Society’s policy work on antimicrobial resistance below.
Knocking Out AMR
-
NAP Survey
In response to the UK’s latest five-year AMR National Action Plan (NAP), “Confronting Antimicrobial Resistance”, the Microbiology Society launched a survey to gather feedback and insights from the microbiology community regarding the content of the NAP. Read the full survey results here.
-
A roadmap for tackling AMR
The Microbiology Society is committed to engaging with policymakers and the media to communicate the expert opinion of the community. Read our Knocking Out AMR policy briefing here.
-
Knocking Out AMR Workshops | Summary Report
In January 2024, the Microbiology Society hosted a series of solution-oriented, invite-only workshops dedicated to our priority solution areas: diagnostics, surveillance, therapeutics and vaccines. Read the full workshop reports here.
-
Harnessing the Irish microbiology community to tackle AMR
As Ireland’s Second One Health Nation Action Plan (iNAP2) on AMR concludes, the Microbiology Society urges a stronger role for researchers in shaping the next phase of national policy. These recommendations are based on views gathered from its community of Irish microbiologists through a series of workshops and surveys held in November and December 2024.
Consultation responses
-
House of Commons Science, Innovation and Technology Committee: Under the microscope inquiry
The Microbiology Society has submitted evidence to the House of Commons Science, Innovation and Technology Committee inquiry into what MPs should put under the microscope. The committee called for input on the questions they should be exploring, and how the government can ensure that science and technology do good for people across the United Kingdom.
-
UK Parliament’s Public Accounts Committee inquiry on Antimicrobial Resistance
The Microbiology Society has submitted evidence to the UK Parliament’s Public Accounts Committee (PAC) inquiry into antimicrobial resistance (AMR), highlighting key challenges and recommendations for strengthening the UK’s response to this growing global crisis. The Society’s response was informed by the views of its members and the wider AMR community through its ‘Knocking Out AMR’ project.
-
NHS England: Antimicrobial Products Subscription Model Consultation
The Microbiology Society submitted a written response to a consultation launched by NHS England, in collaboration with the National Institute for Health and Care Excellence (NICE) and the Department of Health and Social Care (DHSC), on the expansion of the piloted subscription-style payment model for antimicrobial products..
-
Department of Health and Social Care: Antimicrobial Resistance National Action Plan Inquiry
The Microbiology Society submitted a response to a call for evidence launched by the Department of Health and Social Care. This inquiry seeks to establish key priority areas for government intervention, and to gather expert knowledge to inform the new action plan and improve existing policies.
-
House of Commons Science and Technology Committee: The Antimicrobial Potential of Bacteriophages Inquiry
The Microbiology Society submitted a response to a call for evidence launched by the House of Commons Science and Technology Committee on the antimicrobial potential of bacteriophages. The inquiry seeks to establish the strengths and weaknesses of bacteriophage therapy and identify opportunities for the UK government to adapt and improve existing policies.
-
Evaluation of the EU Antimicrobial Resistance Action Plan
The Microbiology Society submitted a letter in response to the public consultation for the Evaluation of the Commission’s Communication to the European Parliament and the Council on the Action Plan against the Rising Threats from Antimicrobial Resistance (AMR) (COM (2011) 748).
-
House of Commons Health and Social Care Committee: Antimicrobial Resistance Inquiry (2018)
The Microbiology Society submitted a written response jointly with the Society for Applied Microbiology to the Health and Social Care Select Committee’s Antimicrobial Resistance (AMR) Inquiry, which looked at what the UK AMR 2013-2018 Strategy has delivered and key actions and priorities for the next UK Government strategy.
-
House of Commons Science and Technology Committee: Antimicrobial Resistance Inquiry (2013)
The Microbiology Society responded to the House of Commons Select Committee on Science and Technology inquiry on antimicrobial resistance.
Briefings
-
Antimicrobial Resistance (AMR) in Wastewater
AMR occurs when disease-causing bacteria, viruses, fungi and parasites (pathogens) are no longer affected by the medicines that have been developed to target them. Drug-resistant pathogens can cause infections that are difficult or impossible to treat; they increase the risk of disease spread and can lead to severe illness, disability and death.
-
Antimicrobial Resistance in the UK: Therapeutics and Vaccines
Antimicrobial resistance (AMR) is an urgent and devastating global health crisis that threatens our healthcare systems, economies, the environment and animal health. Microbiologists across the world are leading the way by working on new innovative solutions to AMR, including developing novel therapeutics and vaccines.
-
Antimicrobial Resistance in the UK: Diagnostics and Surveillance
Antimicrobial resistance (AMR) is an urgent and devastating global health crisis that threatens our healthcare systems, economies, the environment and animal health. Microbiologists across the world are leading the way by working on new innovative diagnostic solutions to AMR.
-
A Sustainable Future: Antimicrobial Resistance Policy Report
The current landscape of AMR research in the UK and Ireland is highly active and expansive. However, the challenge is significant and some aspects of the research must be augmented in order to provide new solutions to infections caused by antimicrobial-resistant organisms.
-
Antimicrobial Resistance Explainer
In 2015 the United Nations (UN) adopted the Sustainable Development Goals (SDGs), a set of targets for the world to achieve by 2030. AMR is a very real threat to achieving the UN SDGs, particularly those associated with poverty, food production, the environment and sustainable economic growth.
Position statements
-
LESPAR response to WHO Global Action Plan on Antimicrobial Resistance (2015)
The Learned Society Partnership on Antimicrobial Resistance (LeSPAR), which comprises the Microbiology Society, Royal Society of Chemistry, Biochemical Society, Society for Applied Microbiology, British Society for Antimicrobial Chemotherapy and Royal Society of Biology, published a statement in response to the approval of the World Health Organization Global Action Plan on AMR.
Image Credits
iStock/NiseriN
iStock/SweetBunFactory
iStock/Mykola Sosiukin
iStock/librededroit
iStock/lucadp
iStock/anyaivanova
iStock/BrasilNut1
iStock/Nicolae Malancea
iStock/AlexRaths
iStock/Alexey Koza
iStock/angelp
iStock/GOCMEN